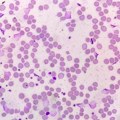
Револуционарно откриће: Нова терапија уништила врсту рака која је до сада била неизлечива

Организације цивилног друштва „на тапету власти“: „У Србији је дијалог постао готово немогућ“
Н1 Инфо 07.08.2024 | Аутор: Н1 Београд

Подели : Најновије истраживање Београдске отворене школе показује да деловање организација цивилног сектора у Србији није на задовољавајућем нивоу.
Оне су у незахвалном положају, пре свега због финансијске одрживости и немогућности да буду равноправни партнер, оценио је програмски директор Београдске отворене школе Владимир Павловић. Павловић је у емисји Дан уживо на Н1 рекао да се цивилно друштво налази пред великим бројем изазова, а два фундаметална су финансијска одрживост и да се избори за улогу партнера у процесу доношења одлука и креирања јавних политика. Он је казао да изостаје прихватање